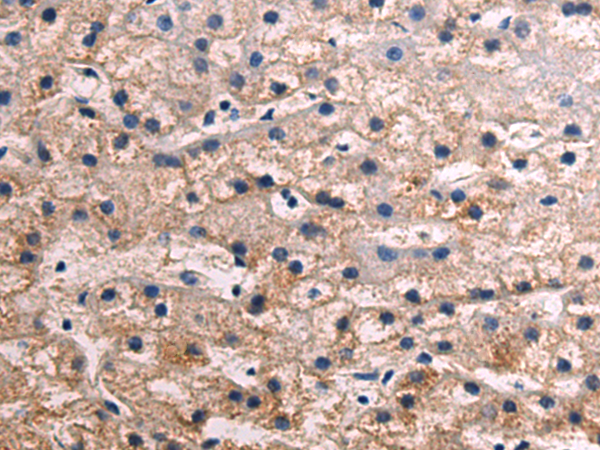
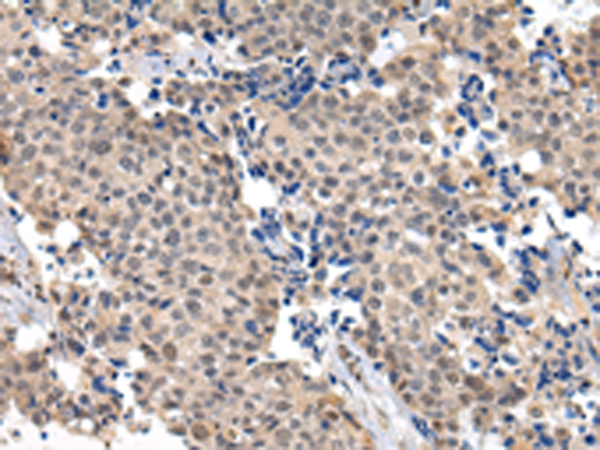

-
分类: 科研抗体货号: P08930别名: UAP; UBAP; NAG20; UBAP-1应用: WB反应种属: Human, Mouse, Rat
-
分类: 科研抗体货号: P08965别名: VAP-A; VAP33; VAP-33; hVAP-33应用: WB,IHC反应种属: Human, Mouse, Rat
-
分类: 科研抗体货号: P08945别名: FNRA; CD49e; VLA-5; VLA5A应用: IHC反应种属: Human, Mouse
-
分类: 科研抗体货号: P08956别名: 65K; SAD1; CGI-21; HSPC332; SNRNP65应用: IHC反应种属: Human, Mouse
-
分类: 科研抗体货号: P08964别名: HPAO; SSAO; VAP1; VAP-1应用: WB反应种属: Human, Mouse, Rat
-
分类: 科研抗体货号: P08944别名: PP5; PPT; PPP5应用: WB,IHC反应种属: Human, Mouse, Rat
-
分类: 科研抗体货号: P08955别名: UEF; FCHL; MLTF; FCHL1; MLTFI; HYPLIP1; bHLHb11应用: IHC反应种属: Human, Mouse
-
分类: 科研抗体货号: P08961别名: TRFP应用: WB,IHC反应种属: Human, Mouse
-
分类: 科研抗体货号: P08943别名: MAP-2; MAP2A; MAP2B; MAP2C应用: WB,IHC反应种属: Human, Mouse, Rat
-
分类: 科研抗体货号: P08960别名:应用: IHC反应种属: Human, Mouse

鄂公网安备42018502007531号
鄂公网安备42018502007531号

